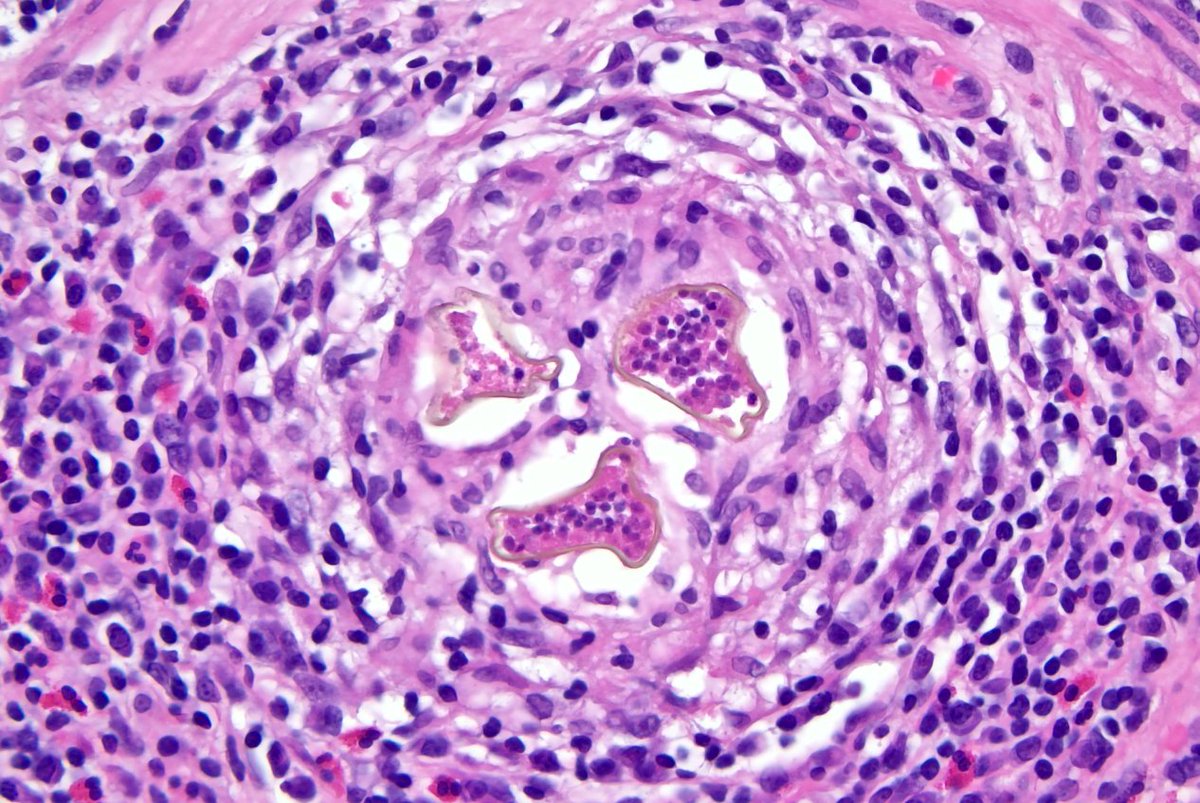
Looking for ideas as to what this, incidental finding in the submucosa of a colon polyp, any thoughts?

#PathTwitter

Stanton Miller
@stanmiller17
PGY-4 path resident, nerd, and aspiring molecular/dermatopathologist.
ID: 1186764049096368128
22-10-2019 21:59:40
558 Tweet
531 Takipçi
332 Takip Edilen

The Division of Hematopathology at UT Southwestern in Dallas, is seeking an energetic and highly motivated individual who is passionate about learning Hematopathology to join our '23–'24 roster of Fellows. 🔬 utsouthwestern.edu/education/medi… HemepathUTSW Olga Weinberg, MD Jesse M. Jaso


Congratulations, Dr. Olga Weinberg! Olga Weinberg, MD Check out "Role of immunohistochemistry and flow cytometry in minimal residual disease detection in NPM1-mutated AML. onlinelibrary.wiley.com/doi/10.1111/ij…




Dr. Hung S. Luu has been appointed to a 3-year term on the Health Information Technology Advisory Committee (HITAC), a national committee that helps the federal government address health information technology challenges. Congratulations! Clinical Informatics Center at UT Southwestern Pediatric Pathology at UT Southwestern UTSW Department of Pathology






Look forward to working with all of them. Very impressed by some of them who rotated with us. Kudos to chiefs Jenny Weon, MD, PhD Stanton Miller for the recruiting efforts. And to our path faculty and staff: we convinced 7 UTSW medical students to purse a pathology career this year!